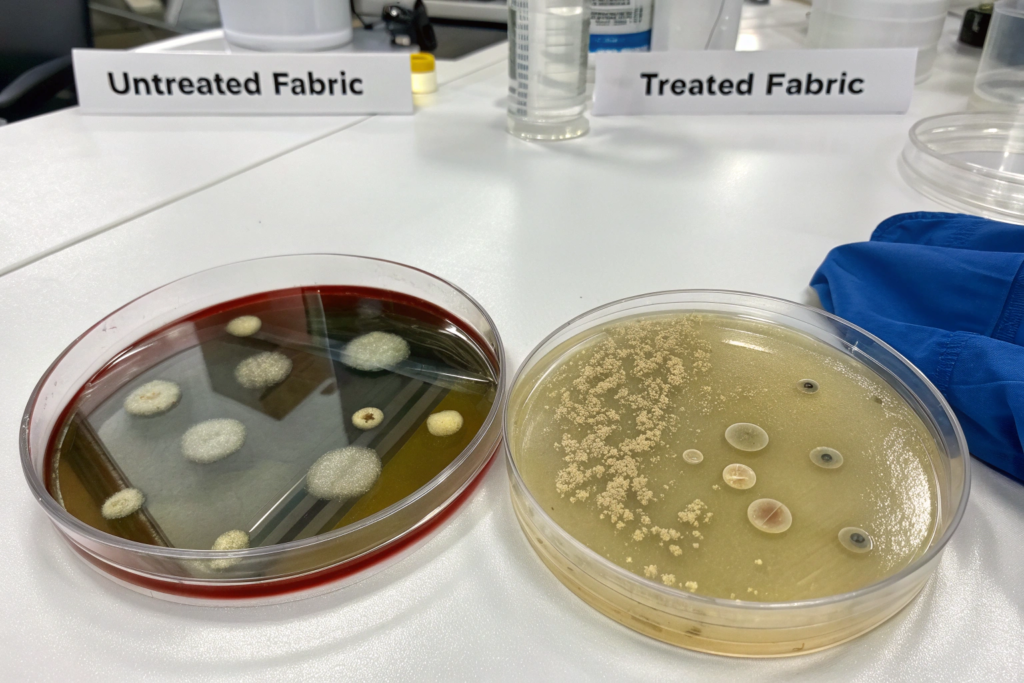

Have you ever pulled a well-used headband out of your gym bag, only to be met with an unpleasant odor? For activewear users, athletes, and retailers, controlling bacteria that cause odors and degradation in sweat-wicking accessories is a persistent challenge. Traditional washing is often not enough.
Silver ion treatments are advanced textile finishing processes where silver, in ionic or nanoparticle form, is durably bonded to headband fabrics. This creates a continuous antimicrobial surface that inhibits the growth of odor-causing bacteria and fungi. It’s a proactive, built-in defense system for the fabric itself.
This technology is transforming performance wear, offering a solution to hygiene, durability, and user comfort concerns. Let's explore how it works, why it's effective, and what it means for your products and customers.
How Do Silver Ions Actually Kill Bacteria on Fabric?
The antimicrobial power of silver ions isn't magic; it's a potent multi-target biochemical attack. Unlike antibiotics that target a specific bacterial process, silver ions disrupt several critical functions simultaneously, making it exceptionally difficult for microbes to develop resistance.
The primary mechanisms involve a one-two punch: cell wall destruction and metabolic shutdown. When silver ions (Ag⁺) come into contact with a bacterial cell, their positive charge is electrostatically attracted to the negatively charged cell membrane. This binding permanently deactivates these proteins, halting the bacterium's energy production and reproductive processes.
Why is This Considered a "Broad-Spectrum" and Durable Antimicrobial?
Silver ions are classified as broad-spectrum antimicrobials because they are effective against a vast array of microorganisms. Research indicates they can kill hundreds of strains of bacteria, fungi, and molds. This includes common odor-causing culprits like Staphylococcus aureus and Escherichia coli, as well as more resistant pathogens. The durability stems from the treatment's longevity. High-quality silver ion treatments, such as those using specific nanocomposites, are designed for slow release. This creates a sustained antimicrobial effect that can survive repeated washing—some treatments maintain significant efficacy through 50 laundry cycles.
What's the Difference Between Silver Ions and Nanosilver?
While the goal is the same, the starting material differs. Silver ion treatments often use silver salts (like silver nitrate or silver saccharinate) that release Ag⁺ ions when in contact with moisture. These nanoparticles can release ions over time and may also have direct physical interactions with microbes due to their tiny size. For headbands, both forms are engineered to be bonded to fibers to ensure they are not easily washed away.
What Are the Real-World Benefits for Headband Users and Sellers?
The application of silver ion technology translates into tangible, marketable benefits that address key user pain points and open up premium product segments.
For the end-user, the most immediate benefit is odor control. By preventing bacteria from breaking down sweat, the headband stays fresher for longer between washes. This enhances comfort and hygiene, especially for athletes or individuals in hot climates. Furthermore, by inhibiting microbial growth, the treatment helps preserve the fabric's integrity. Bacteria and fungi can secrete acids that degrade textile fibers, leading to fading, staining, and premature wear. An antimicrobial headband, therefore, maintains its color and physical properties longer, offering better value.
For retailers and brands like yours, these user benefits create powerful selling points: "Stay-Fresh Technology," "Odor-Resistant," "Hygienic Activewear." It allows for differentiation in a crowded market. Additionally, it caters to the growing demand for functional, low-maintenance, and sustainable fashion by extending the product's usable life.
How Does This Functionality Impact the Care and Lifespan of the Product?
Antimicrobial headbands are generally low-maintenance. They can be machine-washed as usual, but harsh detergents containing bleach or chlorine should be avoided, as these can degrade the silver treatment over time. The true impact on lifespan is two-fold: the fabric is protected from microbial degradation, and because it smells fresh longer, users may wash it less frequently, reducing overall wear and tear from laundry cycles.
Can This Technology Be Combined with Other Functional Treatments?
Absolutely. Silver ion treatments are highly compatible with other textile finishes. A common and synergistic combination is with moisture-wicking treatments. The headband pulls sweat away from the skin quickly (wicking), and the silver ions prevent bacteria from proliferating in that damp environment. Other combinations can include UV protection, anti-static, or water-repellent finishes, allowing for the creation of multi-functional, high-performance accessories.

How Are Silver Ions Applied to Headbands During Manufacturing?
Integrating silver ions into headbands is not a simple spray; it requires specialized textile engineering to ensure the treatment is effective, durable, and safe. Manufacturers use several key techniques, chosen based on the fiber type and desired performance.
The main application methods are exhaustion (or impregnation) and coating. In the exhaustion method, the fabric is immersed in a bath containing a silver compound (like a silver ion solution or nanosilver dispersion). Through controlled temperature and chemical conditions, the silver is drawn into and bonded to the fibers. The coating method involves applying a thin film containing silver directly onto the fabric surface. A specific patent for an antimicrobial headband describes a process where a silver ion polymer solution (e.g., using a product like "Dow Silvadur") is used to form a durable film on a polyester base layer. The choice between these methods affects the hand feel, durability, and cost of the final product.
What is the Role of "Binding" or "Fixing" in This Process?
This is the most critical step. Simply depositing silver on fibers would result in it washing away immediately. The fixing process uses chemical agents or heat to create strong ionic or covalent bonds between the silver particles and the textile fibers. For example, the headband patent mentions a high-temperature drying and curing step (185-200°C) to firmly set the silver-ion polymer film onto the polyester. This ensures the treatment is permanent for the life of the product and safe for skin contact.
Are There Different Formulations for Natural vs. Synthetic Fibers?
Yes, formulations are often tailored. Synthetic fibers like polyester and nylon have a different chemical structure than natural fibers like cotton or bamboo. Silver compounds and binding agents must be chosen to effectively adhere to each type. For instance, treating cotton may involve different silver salts (like silver saccharinate) compared to the polymer-based films used on synthetics. A reputable manufacturer like Shanghai Fumao Clothing will have the expertise and research and development capabilities to select and optimize the right treatment for your chosen headband material, ensuring both performance and compliance.

What Should Buyers Know About Safety and Compliance?
For any brand sourcing antimicrobial products, ensuring safety and regulatory compliance is non-negotiable. This protects both the end-consumer and your brand's reputation.
The core safety principle of silver in textiles is topical, low-dose exposure. When properly bound to fibers, the release of silver ions is minimal and localized to the fabric surface. At these concentrations, it is designed to be effective against microbes but safe for human skin. Rigorous assessments ensure that treatments are non-irritating and non-sensitizing for the vast majority of users.
From a compliance perspective, finished antimicrobial textiles must meet specific international standards. Key certifications to look for include:
- OEKO-TEX Standard 100: Ensures the product is free from harmful levels of regulated substances.
- ISO 18184:2019: The standard for determining the antiviral activity of textile products.
- AATCC Test Method 100 or ISO 20743: Standard methods for assessing antibacterial activity.
- Relevant EPA or FDA Regulations: Depending on the claimed benefits (e.g., "sanitizing" claims may fall under EPA jurisdiction in the US).
How is Long-Term Safety and Environmental Impact Assessed?
Reputable manufacturers conduct leaching tests to measure how much silver, if any, is released from the fabric during washing or use. The goal is "zero" or negligible release into the environment. Furthermore, the durability of the effect is tested through repeated wash cycles to ensure the antimicrobial property is built to last, not a temporary coating that pollutes wastewater. Asking your supplier for test reports from accredited third-party laboratories is a crucial part of due diligence.
What Questions Should You Ask Your Supplier About Their Treatment?
To ensure you are sourcing a high-quality, compliant product, ask direct questions:
- "What specific silver compound or technology do you use, and how is it bonded to the fiber?"
- "Can you provide third-party lab reports for antimicrobial efficacy (e.g., against S. aureus and E. coli) and safety (skin irritation) according to [specific standard]?"
- "What is the expected durability of the effect? Can you show data for antimicrobial activity after 20 or 50 washes?"
- "Does the treatment have any impact on the fabric's breathability, moisture-wicking, or color?"
A transparent supplier will have this data readily available.

Conclusion
Silver ion treatments represent a significant advancement in functional textiles, transforming ordinary headbands into high-performance, hygienic accessories. By leveraging silver's potent and broad-spectrum antimicrobial action, these treatments effectively combat odor, preserve fabric integrity, and enhance user comfort. The technology, involving sophisticated bonding methods like impregnation and coating, provides a durable solution that withstands the rigors of active use and repeated laundering.
For wholesalers, retailers, and brands, this offers a compelling opportunity to differentiate products, meet consumer demand for smart apparel, and add tangible value. The key to success lies in partnering with a knowledgeable manufacturer who prioritizes effective application, rigorous safety testing, and full regulatory compliance.
If you are interested in developing or sourcing high-performance antimicrobial headbands or other activewear accessories, contact our Business Director, Elaine, at elaine@fumaoclothing.com to discuss your project. Let Shanghai Fumao Clothing help you integrate this innovative technology into your next collection.









